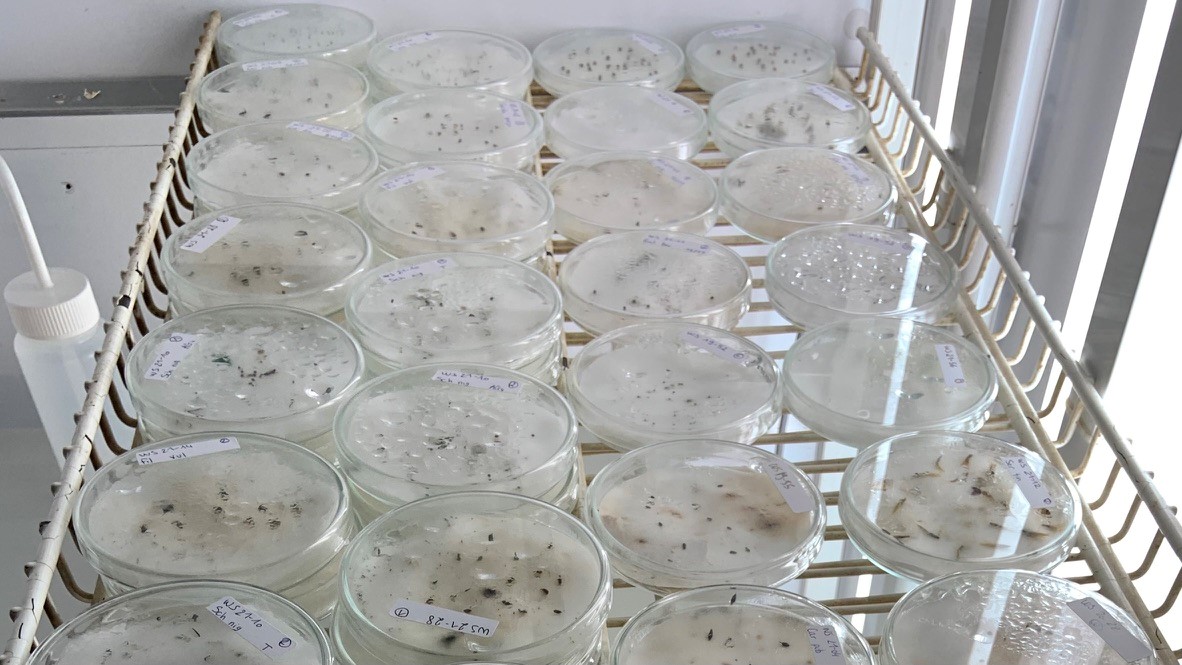
Conservation ex-situ CBN Bailleul

Retour sur la conservation ex-situ
le 09 fév 2022
Baptiste, en service civique au CBN des Hauts-de-France, nous fait un premier retour de son travail de conservation ex-situ.
"En ce mois de janvier, début d’une nouvelle année, c’est le bon moment pour faire un petit bilan de la conservation ex-situ. Depuis mon arrivée en tant que service civique il y a bientôt trois mois, j’ai pu réaliser 103 tests de germination.
Je me suis aussi occupé de remodeler le fichier des données de tous les tests de germination réalisés depuis la création du Conservatoire. Ce nouveau fichier beaucoup plus clair permettra une saisie plus facile des résultats et une analyse et interprétation rapides des données. Cela servira notamment à créer des fiches de données pour beaucoup d’espèces conservées dans la banque de semences. Depuis 1993, 6 573 tests ont été enregistrés dans ce fichier. Cela concerne 478 taxons et 1776 lots."

Exemple d'une fiche de données sur la conservation des semences de Carex pulicaris.